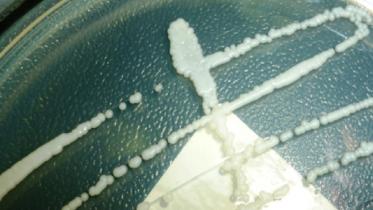
yeast infection.jpg

Uterus transplant
Medical milestone
In a medical first, a mother who received a uterus transplant from a dead donor gave birth to a healthy baby, researchers reported yesterday.
5 December 2018, 18:00 PM
Yeast infection fails first US uterus transplant
The first uterus transplant in the US fails because of yeast infection, Cleveland Clinic, a multispecialty academic hospital located in Cleveland, Ohio, revealed on Friday.
9 April 2016, 14:55 PM
First US uterus transplant fails
The first patient in the United States to receive a uterus transplant had to have the organ removed because of complication, the Cleveland Clinic announces Wednesday.
10 March 2016, 05:20 AM